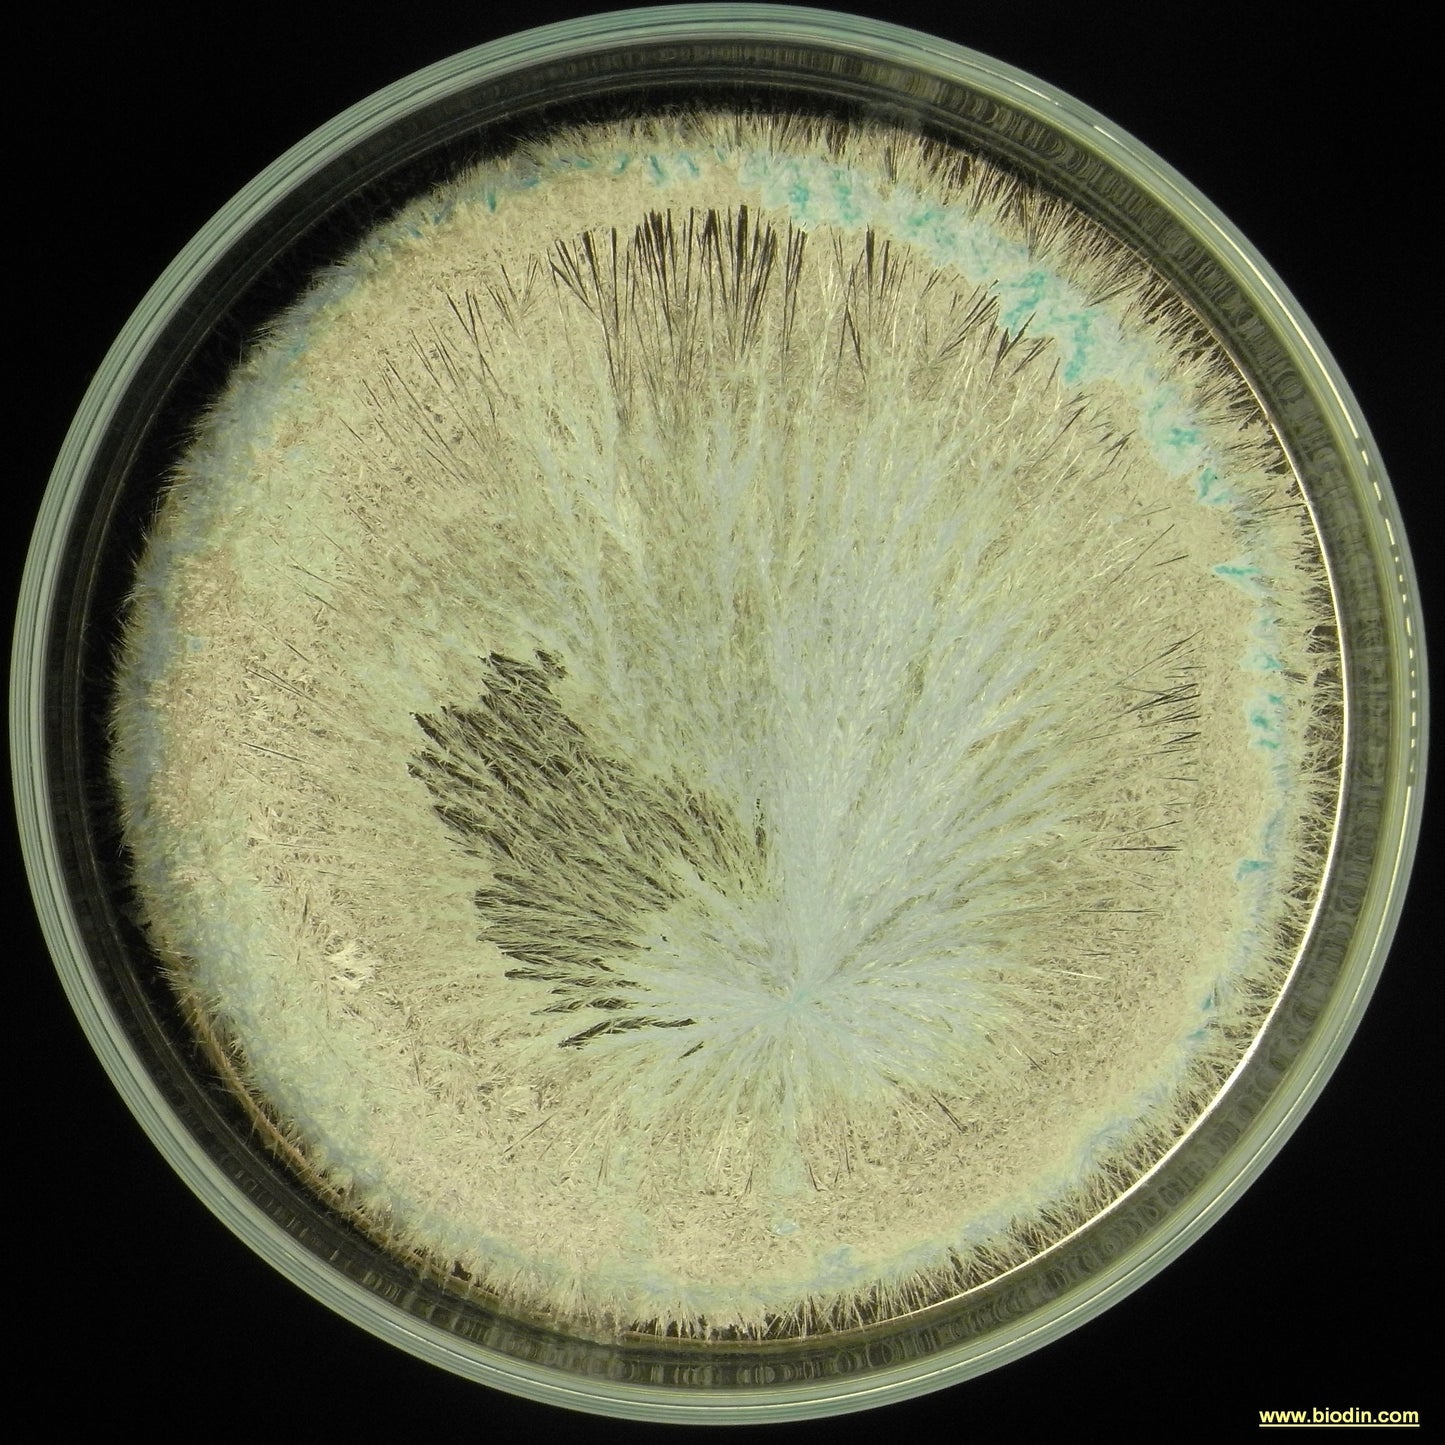

502 PREPARATO DI ACHILLEA
Have a question?

502 PREPARATO DI ACHILLEA
Dettagli
IL 502 o PREPARATO DI ACHILLEA
Che cos'è?
Il preparato di achillea o 502 è allestito a fine maggio, inizio giugno con fiori di achillea millefolium inseriti in una vescica di cervo maschio e lasciata maturare appesa all’aria e poi, da fine settembre, interrata ad una leggera profondità ed estratta a Pasqua. E’ pronta per l’uso nel periodo successivo alla Pasqua (anche se dopo l’estrazione preferisco lasciarla “maturare” ancora per almeno 40 giorni prima di usarla).
Questo preparato, come tutti quelli che vanno dal 502 al 507, viene chiamato “preparato da cumulo”. L’uso di questi preparati, solitamente, è limitato all’allestimento del compost biodinamico. Io li utilizzo anche singolarmente od uniti ad altri preparati facendo riferimento alle prime sperimentazioni degli agricoltori biodinamici che furono elaborate negli anni ’25 - ’35.
R. Steiner spiega che con l’azione di questo preparato lo “zolfo si relaziona in una maniera speciale col potassio” portando nel composto un processo legato al pianeta Venere, pianeta che relaziona la pianta con l’alimentazione.
Queste indicazioni che seguono, non vogliono e non possono essere esaustive per l’uso del preparato, ma semplicemente idee ed indicazioni che ho colto e che metto a disposizione di chi voglia studiare, provare e sperimentare. Va fatto presente che il mondo biodinamico tedesco in genere non approva e considera errato l’uso dei cosiddetti “preparati da cumulo” per uso singolo o diverso dal cumulo …. Ma dato che sono passati oltre 90 anni dal Corso di Koberwitz ed il mondo va avanti occorre studiare usi sempre più completi dei preparati biodinamici e soprattutto anche idearne di nuovi per le nuove problematiche che abbiamo oggi.
Modalità d'uso:
• il 502 si può utilizzare singolarmente od abbinato al 500 quando ci sono carenze di potassio disponibile nel terreno
• questo preparato rende le radici “sensibili” a trovare gli elementi che servono per il loro corretto ed armonioso sviluppo
• l’achillea è legata ai processi dello zolfo, a Venere ed ai segni zodiacali del Toro (azoto) e Bilancia (calcio)
• da usare abbinato al 503, per aumentare la radicazione e la forza della pianta
• sempre R. Steiner nella 5a conferenza del Corso di Koberwitz dice che “I preparati da cumulo portano forza radiante. Con l’achillea si da sensibilità al terreno. Si vivifica la terra per captare le sostanze che fluiscono dal cosmo in dosi omeopatiche.”
• Nella 5a conferenza R. Steiner parla del potassio e della sua importanza nel favorire la crescita della pianta soprattutto nel tronco ed affini, soprattutto la sua struttura.
• Il potassio è la porta fisica affinché la vita del cosmo possa manifestarsi nella materia
• L’achillea è una pianta ricca di processi eterici di zolfo (Venere – Gemelli) e di potassio (Mercurio - Vergine)
• la Vergine , il più grande segno zodiacale, secondo tra tutte le costellazioni, conta ben 2500 galassie e viene considerata la “placenta” dalla quale ha inizio la vita ed il nostro sistema zodiacale
• lo zolfo è la sostanza che permette le relazioni e l’equilibrio tra i componenti della proteina.
• Nell’uomo e nell’animale l’achillea regola e migliora tutto quanto ha una debolezza astrale.
• “Lo zolfo nel processo vegetale in dosi omeopatiche contenuto nell’achillea unito in modo esemplare con il potassio produce un’azione capace di sentire , di percepire , di irradiare” R. Steiner
• R. Steiner dice che il potassio arresta lo sviluppo formando lo stelo e la struttura della pianta.
• Il processo del potassio prende parte ad ogni processo formando e consolidando la sostanza vegetale.
• Nell’achillea il colore del fiore è fortemente raggiante ma neutro e ci indirizza verso la forma intera della pianta.
• “Si intuisce la presenza di un principio che affina la materia e che per manifestarsi attraverso l’immagine preme nella formazione di tutti gli organi , in special modo nelle foglie con la loro fine e mobilissima suddivisione, immagine che però rimane unitaria” R. Steiner
• Nell’achillea il processo dello zolfo è intimamente legato al processo del potassio e sono due processi opposti ma basilari per la vita:
• un respiro Zolfo = espansione, Potassio = concentrazione
• nell’euritmia la Vergine viene rappresentata dalla consonante B
• B significa protezione, abbraccio, sostegno, bacio
• L’achillea è ricca di potassio e zolfo e si vede nella sua forma
• negli appunti del corso di Koberwitz R. Steiner scrive “Il potassio lavora per la formazione di nuove cellule e svolge una attività vitale della proteina vegetale.”
• l’Achillea dopo il 504 (preparato di ortica) ed assieme al 506 (preparato di Tarassaco (usando il metodo di Lilly Kolisko, consigliatole direttamente da R. Steiner è l’unico preparato che fa quasi un anno di maturazione
• Va ricordato anche cosa dice H. Finsterlin a proposito del 502 “La vescica fa nel cervo quanto il calcare fa per i terreni e per il pianeta Terra!”
• I processi del potassio si possono elevare, processare, movimentare, usando il 502, dinamizzando 60 minuti nella dose di 12 grammi per ettaro oppure 100 grammi di fiori secchi in tisana e dinamizzata 20 minuti in acqua
• Usare la tisana di achillea come accompagnatrice nei trattamenti di zolfo: 10 gr. di pianta secca in 5 litri ed allungata in acqua x ettaro
• Col 502 e la tisana di achillea si migliora la protezione dalla ossidazione.
• Spruzzata sui terreni, nebulizzata a gocce a metà tra 500 e 501.
• Per malattie del legno, per piante vecchie, stanche e malate è utile usare il 506 con il 502 assieme
• Il 502 va anche molto bene usato singolarmente contro tutte le parassitosi
• Il 502 permette l’unione ed il collegamento di ciò che sta sopra a ciò che sta sotto. E’ un preparato amorevole e terapeutico perché nel mancato dialogo sta ogni male ed ogni malattia
• Il 502 porta impulsi di verticalità nella parte aerea della pianta
• vi ricordo che è disponibile per uso umano lo sciroppo Agri.Bio di achillea , uno sciroppo con il 20% di estratto di achillea che ho ideato per uso umano
• ecco le sue indicazioni di uso: Aperitiva e digestiva, cicatrizzante delle ulcere gastriche, insieme allo sciroppo di Quercia. Stimola la circolazione del sangue proteggendo e nutrendo vene e capillari.
• Ottima come antiossidante grazie al contenuto elevato di preziosi flavonoidi e per carenze di potassio. Dà la capacità di afferrare le idee, di cogliere le intuizioni quando servono. Certificato Agri.Bio.Dinamica
Un cenno sulla conservazione: di solito il 502 è un preparato che tende a “seccare” e quindi va tenuto sotto controllo spesso, soprattutto se ne avete piccole dosi.
Ogni altra vostra idea o suggerimento, sperimentazione fatta con l’uso del 502 mi sarebbe molto gradita perché solo collaborando e scambiandoci le informazioni siamo veramente umani e cresciamo insieme